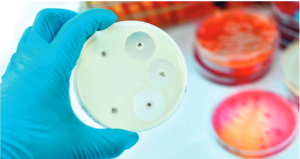

Noticias

Recomendaciones
Agendas Círculo Odontológico del Sur 2024
Muy contentos nos sentimos nuevamente este año 2024, ya que es el cuarto consecutivo, que el Circulo Odontológico del Sur ha podido concretar la realización
Circulo Odontológico del Sur
enero 8, 2024
No hay comentarios

Recomendaciones
Socios COS en Acción
Compartimos con Uds. las iniciativas de algunos de nuestros Socios, quienes apartaron tiempo para solidarizarse con otros y compartir sus conocimientos. La Od. Nievas Nancy
Circulo Odontológico del Sur
noviembre 30, 2023
No hay comentarios

Recomendaciones
15 de Octubre “Día Mundial del lavado de manos”
El Día Mundial del Lavado de Manos se celebra en todo el mundo el 15 de octubre, para recordar la importancia que tiene para la
Circulo Odontológico del Sur
octubre 17, 2023
No hay comentarios

Recomendaciones
Semana Mundial de la Lactancia Materna
Del 01 al 07 de Agosto Salud Bucal Vs Lactancia Materna
Circulo Odontológico del Sur
septiembre 22, 2023
No hay comentarios